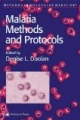
Malaria: Methods and Protocols (Methods in Molecular Medicine)

Malaria - Ursachen, Symptome und Behandlung
Die Malaria ist eine häufig vorkommende Tropenkrankheit mit Fieberschüben. Die Diagnose wird nach einer Blutuntersuchung gestellt. Die Malaria wird durch den Stich einer Mücke übertragen. Wie die Krankheit verläuft, hängt von der genauen Form ab.
Krankheitsbild
Bei Malaria, das auch Wechselfieber oder Sumpffieber genannt wird, handelt es sich um eine fieberhafte Tropenkrankheit. Hervorgerufen wird sie von Plasmodien, einzelligen Organismen.
Weltweit erkranken Jahr für Jahr 250-500 Millionen Menschen an Malaria. Die Krankheit kommt in etwa 100 Ländern vor. Obwohl sie hauptsächlich in tropischen und subtropischen Regionen wie Afrika auftritt, sind aufgrund des globalen Reiseverkehrs auch in Europa etwa 12.000 Malariafälle pro Jahr zu verzeichnen.
Charakteristisch für eine Malaria sind so genannte Fieberschübe in verschiedenen Abständen. Man unterscheidet verschiedene Formen der Malaria. Je nach Krankheitsart treten die Fieberattacken alle 48 oder 72 Stunden oder auch völlig unregelmäßig auf. Im Detail:
- Malaria tertiana mit Fieberschüben alle 48 Stunden
- Malaria quartana mit Fieberschüben alle 72 Stunden
- Malaria knowlesi mit täglichen Fieberschüben und
- Malaria tropica mit Fieberschüben in unregelmäßigen Abständen
Malaria tertiana
Erkrankt ein Mensch an Malaria tertiana, hat er im Grunde genommen noch Glück gehabt, denn sie gehört zu den gutartigen Formen von Malaria, da sie im Gegensatz zu Malaria tropica in der Regel ohne Komplikationen verläuft. Die auslösenden Erreger von Malaria tertiana lassen sich allerdings nur sehr schwer nachweisen.
Malaria tertiana wird von Plasmodium vivax und Plasmodium ovale hervorgerufen. Übertragen werden die Blutparasiten durch eine bestimmte Mückenart, die Anopheles-Mücke, in der sich die Plasmodien befinden. Von Mensch zu Mensch kann die Krankheit dagegen nicht übertragen werden.
In den meisten Fällen beträgt die Inkubationszeit etwa zwei bis drei Wochen. Manchmal kann der Ausbruch der Malaria tertiana aber auch mehrere Monate dauern. Dies ist vor allem dann der Fall, wenn eine Malariaprophylaxe vorgenommen wird. Eine solche Maßnahme verhindert zwar nicht den Ausbruch der Krankheit, verlangsamt ihn jedoch.
Malaria quartana
Ebenso wie Malaria tertiana, gehört Malaria quartana zu den gutartigen Malaria-Formen. Da die Symptome dieser Verlaufsform die geringsten Auswirkungen aller Malaria-Arten auf die Gesundheit haben, sieht man sie als leichteste Malariaerkrankung an. Ein weiterer Unterschied ist, dass die Inkubationszeit, die Zeit zwischen Infektion und Ausbruch der Krankheit, 16 bis 50 Tage beträgt, was deutlich länger ist als bei Malaria tertiana oder Malaria tropica.
Als problematisch gilt der Umstand, dass Malaria quartana nicht immer vollständig auskuriert wird, wodurch es sogar noch nach Jahrzehnten erneut zum Ausbruch der Krankheit kommen kann. Darüber hinaus besteht die Gefahr, dass die Malaria vom behandelnden Arzt gar nicht erkannt und entsprechend therapiert wird. Die Symptome bei Malaria quartana sind ähnlich wie bei Malaria tertiana.
Malaria tropica
Die gefährlichste Malariaform von allen ist Malaria tropica, denn sie kann schlimmstenfalls sogar zum Tode führen. Die Inkubationszeit, also der Zeitraum zwischen Infektion und Ausbruch der Krankheit, beträgt bei Malaria tropica ein bis zwei Wochen.
Ursachen
Durch den Stich einer bestimmten Mückenart wird der Malariaerreger auf den Menschen übertragen. Die infizierte Mücke befindet sich ausschließlich in den Tropen.
Sie überträgt vier verschiedene Formen von Malariaerregern, die zu drei verschiedenartigen Erkrankungen führen. Die einzelnen Krankheitsformen unterscheiden sich in der Häufigkeit der Fieberschübe (alle 48 bzw. 72 Stunden oder unregelmäßig).
Die Erreger, so genannte Plasmodien, werden durch den Speichel der Mücke beim Einstich in den Körper des Menschen übertragen. Bis sich die ersten Symptome zeigen, vergehen im Schnitt wenige Wochen.
Man unterscheidet je nach Malariaform folgende Krankheitsüberträger:
- Plasmodium vivax und Plasmodium ovale (Malaria tertiana)
- Plasmodium malariae (Malaria quartana)
- Plasmodium knowlesi (Malaria knowlesi) sowie
- Plasmodium falciparum (Malaria tropica)
In einigen Fällen können die Malariaerreger auch über unsaubere Injektionsnadeln oder durch unzureichend geprüfte Bluttransfusionen übertragen werden. Zu einer Ansteckung von einer Mutter auf ihr ungeborenes Kind kann es durch eine Verletzung der Plazenta kommen, was aber nur selten der Fall ist.
Besonders hoch ist das Infektionsrisiko in Malariagebieten. Mitunter kommt es auch durch von Flugreisenden eingeschleppte Mücken zu Krankheitsfällen außerhalb von Malariagebieten. Mediziner sprechen dann von einer Flughafen-Malaria.
Verlauf
Die Malariaform, bei der unregelmäßige Fieberschübe auftreten, ist die schlimmste Malariaform. Sie führt bei etwa jedem dritten Patienten zum Tode. Wird sie jedoch rechtzeitig behandelt, bestehen gute Heilungschancen.
Gleiches gilt auch für die anderen Malariaformen. Die Patienten versterben auch ohne Behandlung nur selten, die Krankheiten dauern dann jedoch bis zu drei Jahre lang an.
Malaria tertiana und Malaria quartana verschwinden selbst ohne Behandlung nach etwa zwei bis drei Jahren wieder von allein. Zur Behandlung werden dem Patienten bestimmte Medikamente verabreicht. Bei rechtzeitiger Behandlung mit den erwähnten Mitteln ist der Verlauf von Malaria tropica meist positiv.
Mit welchen Beschwerden die Krankheitsverläufe einhergehen, erfahren Sie im nächsten Punkt.
Symptome
Zu Beginn der Erkrankung leiden Patienten mit einer Malaria ganz plötzlich unter Schmerzen im Bereich des Rückens und Kopfes verbunden mit hohem Fieber. Der Patient friert und gleichzeitig ist ihm auch heiß. Auch Gliederschmerzen und Durchfall können zu den Symptomen gehören.
Malaria tropica
Die Malariaform, in der das Fieber unregelmäßig auftritt, ist die schwerste Form der Erkrankung. Folge dieser Krankheitsform kann eine Gehirnbeteiligung sein, die mit einem tödlichen Koma endet.
Durch diese Malariaform können auch etliche innere Organe in Mitleidenschaft gezogen werden. Es kommt zu
Ein großes Risiko bei Malaria tropica sind lebensgefährliche Komplikationen wie die zerebrale Malaria. Diese macht sich zunächst durch Benommenheit bemerkbar, führt im weiteren Verlauf zu einem Koma und endet oft tödlich. Des Weiteren besteht die Gefahr von Schädigungen der Lunge, der Nieren, des Magen-Darm-Trakts und des Herzens.
Malaria tertiana
Die Malariaform wird deshalb Malaria tertiana genannt, weil die Fieberschübe der Erkrankung drei Phasen haben. Allerdings ist der Rhythmus der Fieberschübe ähnlich unspezifisch wie bei den beiden anderen Malariaformen. Meistens dauern die Fieberanfälle nur wenige Stunden, wiederholen sich aber regelmäßig.
Das erste Stadium wird als Froststadium bezeichnet. Dabei leidet der Patient unter starkem Schüttelfrost und einem deutlichen Anstieg der Körpertemperatur.
Im zweiten Stadium, dem Hitzestadium, können auch Übelkeit und Erbrechen auftreten und das Fieber kann auf bis zu 40 Grad Celsius ansteigen.
Die dritte Phase nennt man Schweißphase. Dabei leidet der Patient unter heftigen Schweißausbrüchen und die Körpertemperatur sinkt wieder. Zur Schädigung von Organen, wie bei Malaria tropica, kommt es jedoch nicht.
Malaria quartana
Obwohl Malaria quartana zu den gutartigen Malariaformen gezählt wird, kann es dennoch zu schwerwiegenden Komplikationen kommen. Dazu gehört vor allem das nephrotische Syndrom, das man in der Medizin auch als Malarianephrose bezeichnet. Dabei bilden sich Ödeme in der Bauchhöhle und den Nieren.
Darüber hinaus besteht die Gefahr, dass der Cholesterinwert im Blutserum stark ansteigt und das Eiweiß Albumin auf einen niedrigen Wert abfällt. Albumin ist zuständig für den Abtransport von Wasser aus dem Blutkreislauf.
Zu dieser Komplikation kommt es vorwiegend bei erkrankten Afrikanern. Europäische Touristen, die an Malaria quartana erkranken, sind dagegen kaum betroffen.
Diagnose
Die Malaria zeigt ähnliche Symptome wie eine Grippe, so dass besonders die Diagnosestellung der Malariaform mit den unregelmäßigen Fieberschüben schwierig ist. Wenn ein Patient jedoch erwähnt, dass er sich in einem Malariagebiet befand, muss der Arzt sofort auf diese Diagnose tippen.
In jedem Fall erfolgt eine Blutabnahme. Nur so kann die Malaria mit Sicherheit diagnostiziert werden. Im Rahmen der Blutuntersuchung fällt meist auch eine Blutarmut auf.
Die Erreger der Malaria können im Blut unter dem Mikroskop festgestellt werden, so dass daraufhin die gesicherte Diagnose erfolgen kann. Wird der Erreger diagnostiziert, muss dies dem Gesundheitsamt gemeldet werden.
Therapie
Eine Malaria kann durch die Einnahme vieler verschiedener Medikamente behandelt werden. Nicht immer spricht der Patient jedoch sofort auf das erste dieser Medikamente an, da die Erreger teilweise resistent gegen die Präparate sind. In einigen Fällen müssen daher verschiedene Medikamente ausprobiert werden, bis die Therapie anschlägt.
Grundsätzlich muss die Behandlung einer Malaria so früh wie möglich begonnen werden; meist wird nicht einmal das Laborergebnis abgewartet. Sehr wirksam in der Malariabehandlung ist das Medikament Chinin. Die Patienten können es entweder in Tablettenform einnehmen oder der Arzt spritzt das Medikament in die Armvene. Zu den weiteren Wirkstoffen zählen Choloroquin sowie Melfloquin.
Die Malaria stellt eine meldepflichtige Erkrankung dar. Der Arzt bzw. das Labor müssen demnach eine Meldung an das Gesundheitsamt machen, wenn sie Malariaerreger im Blut feststellen konnten. Eine Impfung gegen Malaria ist nicht möglich.
Vorbeugung: Malariaprophylaxe
Wer einen Aufenthalt in den Tropen plant, sollte sich bei spezialisierten Ärzten über das Risiko einer Malariaerkrankung und die vorbeugenden Maßnahmen informieren. Man unterscheidet zwei Maßnahmen zur wirksamen Malariaprophylaxe:
- die Expositionsprophylaxe (Vermeidung von Isektenstichen) und die
- Chemoprophylaxe (Einnahme von Malariamitteln)
Meist wird den Patienten zur Vorbeugung ein spezielles Medikament verordnet, das die Patienten vor ihrer Reise einnehmen müssen. Es handelt sich dabei um das gleiche Medikament, das auch zur Behandlung der Krankheit verwendet wird. Nicht immer kann die Malaria dadurch jedoch auch verhindert werden.
Man sollte daher in den Tropen zusätzlich zur medikamentösen Prophylaxe darauf achten, nicht von Mücken gestochen zu werden. Dazu gibt es spezielle Moskitonetze, die man über dem Bett aufhängen kann.
Abends sollte man nur langärmelige Oberteile und lange Hosen tragen. Die Kleidungsstücke sollten aus einem hellen Stoff sein. Zusätzlich gibt es auch Anti-Mücken-Präparate, die auf die Haut aufgetragen oder aufgesprüht werden.
Detailliertere Informationen in Sachen Malariaprophylaxe erhalten Sie hier.
Passend zum Thema
Tropenkrankheiten - Ursachen, Symptome und Behandlung
Mückenstiche - Ursachen, Symptome, Behandlung und Vorbeugemöglichkeiten
Typische Reisebeschwerden und Tipps zur Bekämpfung
Insektenstiche - Ursachen, Symptome, Behandlung und Vorbeugemöglichkeiten
Aufgaben, Ausbildung und Weiterbildung eines Reisemediziners
Parasitenbefall - Ursachen, Symptome und Behandlung
Fieber - Ursachen und Behandlung
Akutes Nierenversagen - Ursachen, Symptome, Behandlung und Vorbeugemöglichkeiten
- Avian Malaria in the Asian Tropical Subregion, Springer-Verlag Singapore Pte. Ltd., ISBN 9813083190
- Malaria, Uni-Med, Bremen, 2002, ISBN 3895996238
- Malaria (Deadly Diseases and Epidemics), Chelsea House Publications, 2004, ISBN 0791074668
- Malaria, Fleckfieber, Pest, Hirzel, Stgt., 1985, ISBN 377760416X
- Malaria: A Hematological Perspective (Tropical Medicine: Science and Practice), Imperial College Press, 2004, ISBN 1860943578
- Grundwissen Medizin: für Nichtmediziner in Studium und Praxis, UTB GmbH, 2017, ISBN 3825248860
- Praxisleitfaden Allgemeinmedizin: Mit Zugang zur Medizinwelt (Klinikleitfaden), Urban & Fischer Verlag/Elsevier GmbH, 2017, ISBN 3437224476
- Gesundheits- und Krankheitslehre: Lehrbuch für die Gesundheits-, Kranken- und Altenpflege, Springer Medizin Verlag, 2013, ISBN 9783642369834
- Medizinwissen von A-Z: Das Lexikon der 1000 wichtigsten Krankheiten und Untersuchungen, MVS Medizinverlage Stuttgart, 2008, ISBN 3830434545
- Lexikon der Krankheiten und Untersuchungen, Thieme Verlagsgruppe, 2008, ISBN 9783131429629
- Netter's Innere Medizin, Thieme Verlagsgruppe, 2000, ISBN 3131239611
- Innere Medizin 2019, Herold, 2018, ISBN 398146608X
- Innere Medizin 2020, Herold, 2019, ISBN 3981466098
- Repetitorium für die Facharztprüfung Innere Medizin: Mit Zugang zur Medizinwelt, Urban & Fischer Verlag/Elsevier GmbH, 2017, ISBN 3437233165
- Impfungen für Auslandsreisende und Malariaprophylaxe. Vademecum für niedergelassene Ärzte., Facultas, 2001, ISBN 3850765385
Unsere Artikel werden auf Grundlage fundierter wissenschaftlicher Quellen sowie dem zum Zeitpunkt der Erstellung aktuellsten Forschungsstand verfasst und regelmäßig von Experten geprüft. Wie wir arbeiten und unsere Artikel aktuell halten, beschreiben wir ausführlich auf dieser Seite.
-
Bugs in Armor: A Tale of Malaria and Soldiering, iUniverse, 2000, ISBN 1583487549 -
Malaria Parasites: Genomes and Molecular Biology, Caister Academic Press, 2004, ISBN 0954246462 -
Disease in the History of Modern Latin America: From Malaria to AIDS, Duke University Press, 2003, ISBN 0822330695 -
Orale Behandlung mit ß-Artemether (ArtenamR( und Sulphadoxin-Pyrimethamin (FansidarR) bei chloroquinresistenter Falciparum-Malaria bei Kindern im Kamuli Distrikt, Uganda, Tectum Verlag, 2002, ISBN 3828812643 -
Traditionell gegen Malaria eingesetzte Arzneipflanzen: : In-vitro-Aktivität pflanzlicher Extrakte und isolierter Naturstoffe aus dem Phenylpropan- und Terpen-Stoffwechsel, Der Andere Verlag, ISBN 3899590643 -
Saving Lives, Buying Time: Economics of Malaria Drugs in an Age of Resistance, National Academies Press, 2004, ISBN 0309092183 -
Quantenmechanische Mechanismusstudien zur Steuerung stereoselektiver Reaktionen und 3D-QSAR-Untersuchungen antimalaria-aktiver Naphthylisochinolin-Alkaloide, Tectum Verlag, 1999, ISBN 382880568X -
Essential Malariology, Arnold Publishers, 2002, ISBN 0340740647 -
Malaria: Methods and Protocols (Methods in Molecular Medicine), Humana Press, 2002, ISBN 0896038238 -
Ronald Ross: Malariologist & Polymath, a Biography, St. Martin's Press, 1997, ISBN 0312162960 -
The Contextual Determinants of Malaria, Resources for the Future, 2002, ISBN 1891853198 -
Quinine: Malaria and the Quest for a Cure That Changed the World, Perennial, 2004, ISBN 0060959002 -
The Miraculous Fever-Tree: Malaria and the Quest for a Cure That Changed the World, HarperCollins Publishers, 2003, ISBN 0060199512 -
Malaria: Waiting for the Vaccine, John Wiley and Sons Ltd, 1991, ISBN 0471931004 -
Malaria - A Medical Dictionary Bibliography and Annotated Research Guide to Internet References, Icon Group Intl Inc, 2003, ISBN 0597836272 -
Malaria: Obstacles and Opportunities, National Academies Press, 1991, ISBN 0309045274 -
Passive elektrogene Transportprozesse durch die Membran von Humanerythrozyten und Erythrozyten von gesunden und Malaria-infizierten Hühnern, Logos Verlag Berlin, ISBN 3897225115 -
We Won't Budge: A Malaria Memoir, Basic Civitas Books, 2003, ISBN 0465017096 -
Malaria Shots Not Included: A Guide to Surviving Life After College, Xlibris Corporation, 2000, ISBN 0738817287 -
Malaria: Poverty, Race, and Public Health in the United States, Johns Hopkins University Press, 2001, ISBN 0801866375 -
The Fever Trail: In Search of the Cure for Malaria, Picador USA, 2003, ISBN 031242180X -
The Fever Trail: Malaria, the Mosquito and the Quest for Quinine, Pan, 2002, ISBN 0330481851 -
The Fever Trailour Passages, Farrar Straus Giroux, 2002, ISBN 0374154694 -
Malaria: A Layman's Guide (South African Travel & Field Guides), Southern Book Pub of South Africa, 1999, ISBN 1868125343 -
Malaria, CRC Press, 1999, ISBN 9057024462 -
Traditional Medicinal Plants and Malaria E of Genomics (Traditional Herbal Medicines for Modern Times), Taylor & Francis Group, 2004, ISBN 0415301122 -
Cytotoxic T-Lymphocytes in Human Viral and Malaria Infection, Springer, B., 1994, ISBN 3540572597 -
Molecular Immun Considerations in Malaria Vaccine Development, Crc Pr I Llc, 1993, ISBN 0849352584 -
Malaria (Epidemics), Rosen Pub Group, 2001, ISBN 0823933423 -
West Nile, Malaria, and Other Mosquito-Borne Diseases (Diseases and People), Enslow Publishers, 2001, ISBN 0766015971 -
Travelers Malaria with CDROM, B.C. Decker Inc, 2001, ISBN 1550091573 -
Malaria in Pregnancy, CRC Press, 2002, ISBN 0415272181 -
Anglo-European Science and the Rhetoric of Empire: Malaria, Opium, and British Rule in India, 1756-1895, Lexington Books, 2003, ISBN 0739105841 -
Malaria Control During Mass Population Movements and Natural Disasters, Natl Academy Pr, 2003, ISBN 0309086159 -
Malaria Immunology, Karger, 2002, ISBN 3805573766 -
Malaria Capers. Tales of Parasites and People, W. W. Norton & Company, 1993, ISBN 0393310086 -
Malaria and Rome. A History of Malaria in Ancient Italy, Oxford University Press, 2002, ISBN 0199248508 -
Epidemien. Das große Sterben der Indianer. Pocken, Masern, Grippe, Fleckfieber, Cholera, Malaria, BoD GmbH, Norderstedt, 2003, ISBN 3833005831 -
Malaria Vaccine Development: A Multi-Immune Response Approach, American Society Microbiology, 1996, ISBN 1555811116 -
Malaria Dreams: An African Adventure (Abacus Books), Abacus, 1992, ISBN 0349102112 -
Malaria, Vintage, 2001, ISBN 0099283344 -
Malaria Frontline: Australian Army Research During World War II, Melbourne University Press, 2003, ISBN 0522850332 -
Genes and Resistance to Disease, Springer Verlag, 2000, ISBN 3540667245